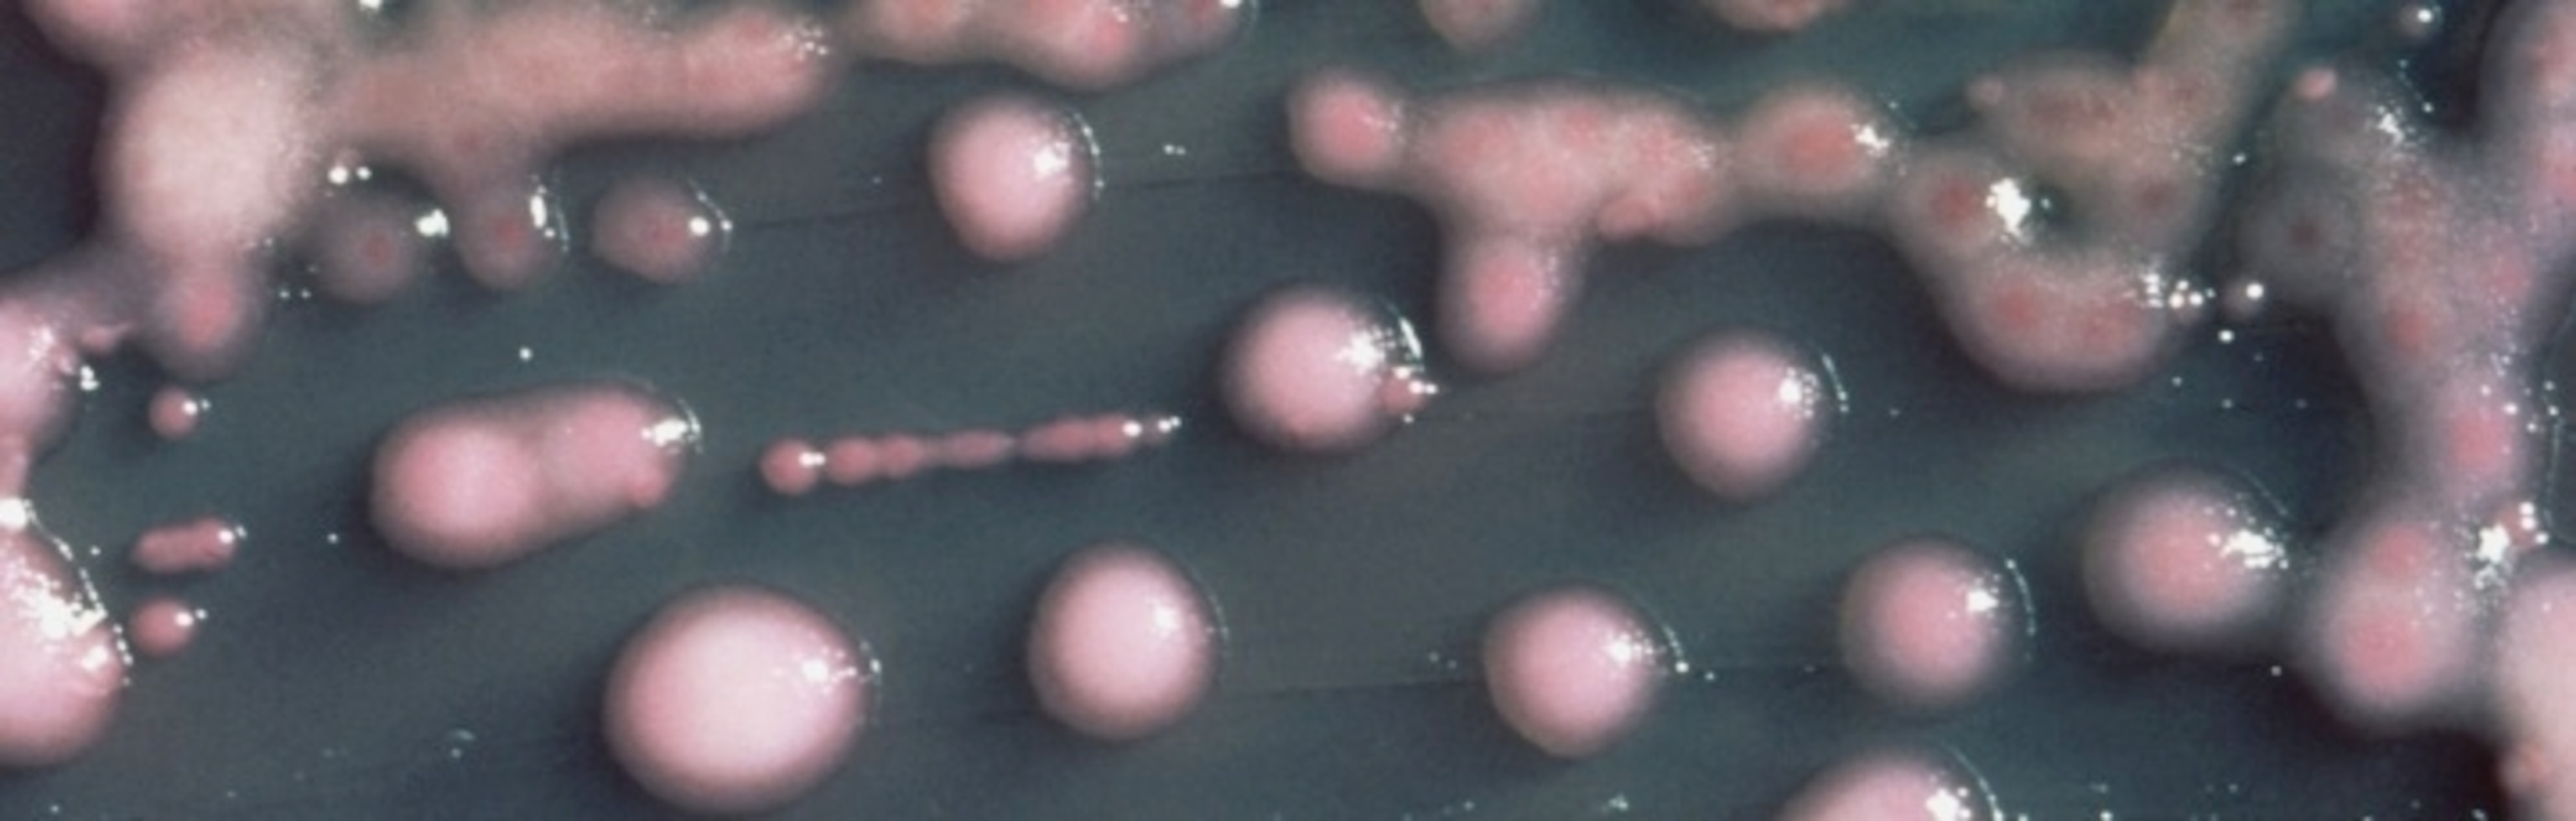

Earlier this week, the Centers for Disease Control warned that we’re facing an onslaught of “nightmare bacteria”–a group of highly resistant, highly deadly microbes. Talk of the Nation, the National Public Radio Show, asked me to join them to talk about these bugs yesterday. You can listen to it here:
This is the sort of story that seems tailor-made for confusion, thanks to the squirrelly nature of microbiology. As my fellow guest on the show, NPR science correspondent Rob Stein, observed, we are not dealing with an out-of-control plague that will wipe out the planet. On the other hand, as I pointed out, these nightmare bacteria are killing people, and will probably kill more people in the future. I’m sure that listeners were left scratching their heads a bit. So I wanted to take a moment this snowy morning to explain the news at more length.
Not long after scientists invented antibiotics in the mid-1900s, they started observing bacteria that were becoming resistant to the drugs. Some of the microbes carried mutations that made them a little less susceptible, so that a few of them survived the onslaught and could reproduce. Their descendants mutated more, and some became more resistant.
At the same time, genes were slipping from one microbe to another–even leaping the species barrier–and that made things even worse. For one thing, the bacteria that make us sick could tap into the vast repository of resistance genes in the other bacteria dwelling in our bodies and in the soil. The bacteria could load several resistance genes into the same piece of DNA, becoming resistant not just to one drug, but to many.
For decades, microbiologists have been warning that resistance was rising, and that things were going to get worse. And worse they did become. Fearsome strains of bacteria emerged, such as methicillin-resistant Staphylococcus aureus, now familiar by its acronym MRSA. (For the full story of MRSA, read Maryn McKenna’s award-winning book Superbug. And then read all her other stuff too.)
This week the CDC raised a warning about a different kind of bacteria, called CRE for short. That stands for carbapenem-resistant Enterobacteriaceae. (I can hear you saying, “Um, is it okay if I just call it CRE?” I’m here to tell you yes.)
Enterobacteriaceae refers to a large taxonomic group of bacterial species. It includes some familiar bugs, like E. coli, as well as many you’ve never heard of. Only some of them live in the human body, and only some of those strains have the potential to make us sick. (You probably have a few billion E. coli in your gut right now. But if you get one of the nasty E. coli strains, you may get organ failure or die.)
Okay, that takes care of the E in CRE. CR refers to the ability of some of these strains to resist carbapenems, which are a class of potent antibiotics. When they were first developed, they were a godsend, because doctors could use them against bacteria that had become resistant to older drugs like penicillin. But in the 1990s and early 2000s, hospitals started seeing bacteria–members of the Enterobacteriaceae, spefically–that had evolved enzymes that they used to chop up the carbapenems.
One of the worst of these offenders is a strain of Klebsiella called KPC. I just wrote about an outbreak of KPC at a major research hospital for Wiredan outbreak of KPC at a major research hospital for Wired, and I hope that my story gets across what a nightmare these outbreaks can be. These bacteria can ride silently on healthy people from room to room, from ward to ward, from hospital to hospital. And then they can strike vulnerable patients. Since these bacteria can resist carbapenems, doctors are left with few options. They can use a few truly nasty drugs that were abandoned decades ago because they were so toxic. And, as I write in my Wired feature, the bacteria can evolve resistance even to those drugs in the body of a single patient. And then it’s game over. As a result, CREs can be up to 50% fatal.
KPC is just one of the CRE bacteria doctors are worried about. In India, a new set of resistance genes has emerged that go by the name NDM-1. Several different species carry them, and they’re not limited to hospitals. Scientists have even found NDM-1 germs in ordinary tap water. Once these genes evolve, they don’t stay put. NDM-1 has made its way to the United States–possibly thanks in part to medical tourism. Meanwhile, KPC–which got its start on the east coast of the United States–has spread to many countries overseas.
Most of the trends for CRE are going in the wrong direction. New kinds of resistance genes are evolving and spreading to different species. Those resistant strains are showing up in more states and more countries. The percentage of these bacteria that are resistant is increasing. The CDC’s announcement this week was spurred by a recent survey they did. They found that 4.6% of the hospitals they surveyed had one CRE infection in the previous six months. And eighteen percent of long-term care facilities had one, too.
These are worrying figures, when you consider that previous generations of doctors simply didn’t have to contend with CRE. Strains like KPC just didn’t exist. On the other hand, the percentages are still fairly low. I asked a doctor who works at a hospital in a small Connecticut city what she thought about the report. She said, “Well, you hear about outbreaks at other hospitals, and you just hope it doesn’t come here.”
Unfortunately, there’s not much stopping it from coming here, and everywhere. That doesn’t mean that there’s nothing to be done. We just need to get our collective act together. Here are a few things that many experts are agreeing would help:
–Get the data. Right now, there are few states that demand that hospitals report the presence of CREs. If there was a nation-wide database, it would become possible to organize large-scale campaigns against the bacteria. If more hospitals get the means to sequence genes of the bacteria, they might even be able to track individual outbreaks from hospital to hospital.
–Get serious. Israel faced a KPC outbreak in 2007 and went a long way to reducing infection rates. They did so with a national campaign. When they saw hospitals getting hit by the bacteria, they required some tough measures be put in place. I describe some of those measures in my Wired story. Isolate the infected patients. Test other patients regularly with accurate tests. Dedicate nurses and doctors to the infected patients and don’t let them get near other patients. Bomb hospital rooms with bacteria-scrubbing chemicals. Wash hands. Wash them again. Put people in the wards whose job it is to go up to the chief of surgery and say, “You didn’t take two squirts of hand gel. That’s the rule.” Some experts are even suggesting that hospital doctors always wear gowns and gloves. It’s a pain in the neck, to be sure, but dentists already do it, so why not doctors?
–Become good stewards of antibiotics. It’s not surprising that NDM-1 took off in India, because you can walk into a drug store there and buy antibiotics without a prescription. That’s a fabulous way to breed resistant bacteria. Likewise, many scientists are warning that feeding antibiotics to farm animals breeds resistance and then make its way back to the bacteria that make us sick. The antibiotics free-for-all has to end.
Here’s one thing that’s especially scary about CREs: one of the biggest risk factors for acquiring them is having taken antibiotics to treat another infection in the previous few months. As I wrote here in December, antibiotics are not picky about who they kill. They can destabilize your microbial ecosystem, allowing invasive species to push their way in. Doctors have to become more careful with using antibiotics, and scientists have to explore alternatives, such as repopulating ecosystems with transplanted bacteria.
–Get the antibiotics pipeline flowing again. What makes the current crisis with CRE so scary is that we have just about nothing left in our arsenal, and we won’t be getting new antibiotics that are effective against CRE any time soon. The market incentives for developing antibiotics are dismal: these are very expensive drugs to develop and test, but the potential profits to be made from them are not enticing. In fact, if someone came out with a powerful new antibiotic against CRE today, doctors would say, “Thank you so much,” and then put it on their shelf, to save in case other antibiotics failed. There are bills being considered by Congress now to rejigger the incentives to get the antibiotics pipeline flowing again.
–Look beyond CRE. MRSA were once the organisms du jour. Now it’s CRE. Hospitals are being told to stay vigilant against each of these types of bugs in isolation. But that would be a bit like telling a country to prepare for a naval invasion, when the enemy has planes, missiles, and ground troops, too. There are several groups of dangerous bugs invading hospitals, and there will be new ones evolving in years to come. And, to completely shatter my military metaphor, the genes from one group may end up in another. Unfortunately, hospitals can’t test for a dozen species or genes at once. They simply lack the technological capacity. They need it.
Making matters worse, going after one group of bacteria at a time may potentially make things worse overall. For example, one way to fight MRSA is to use an antiseptic called chlorhexidine. This turns out to favor CRE. If you use alcohol hand rubs to fight MRSA and CRE, you may open the door to bacteria called Clostridium difficile.
Richard Wenzel and Michael Edmond of Virginia Commonwealth University have dubbed this one-at-a-time strategy a vertical interventional control program. They call instead for horizontal programs–in other words, recognize that we are fighting against lots of species at once and develop strategies for them all.
Up to ten percent of patients admitted to hospitals will acquire an infection. At least 90,000 people die in the United States alone of these hospital-acquired infections. It won’t be easy to fight these bacteria, but just sitting back is unacceptable. We know that more people will die.